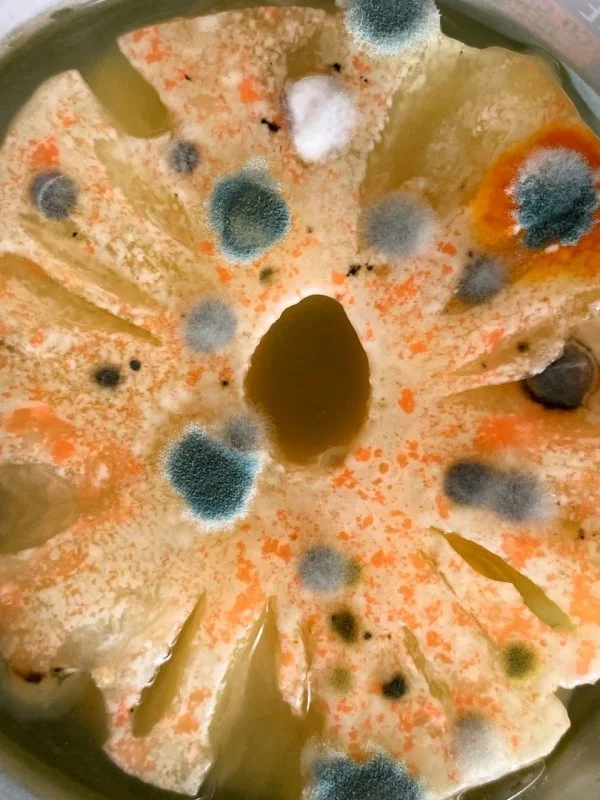

Пожалуй, что у всех слово "плесень" ассоциируется с чем-нибудь неприятным. А между в прочим в ней есть своя красота и эстетика. Это доказали авторы этих крутых снимков, которые сфотографировали еду, о которой надолго забыли. Выглядит действительно инопланетно.
Когда-то это был чай 
Вишня в сиропе 
Лимон, который месяц пробыл в холодильнике 
Свёкла 
Спагетти Болоньезе 
Нейронные связи в квасе 
Батон 
Плесень-антистресс в бражке 
Консервированный ананас
Тарталетка 
Пыльные дюны сыра фета 
Лизун решил, что ему мало блёсток, поэтому он добавил ещё 
Вода из-под зелёного горошка 
0 комментариев





